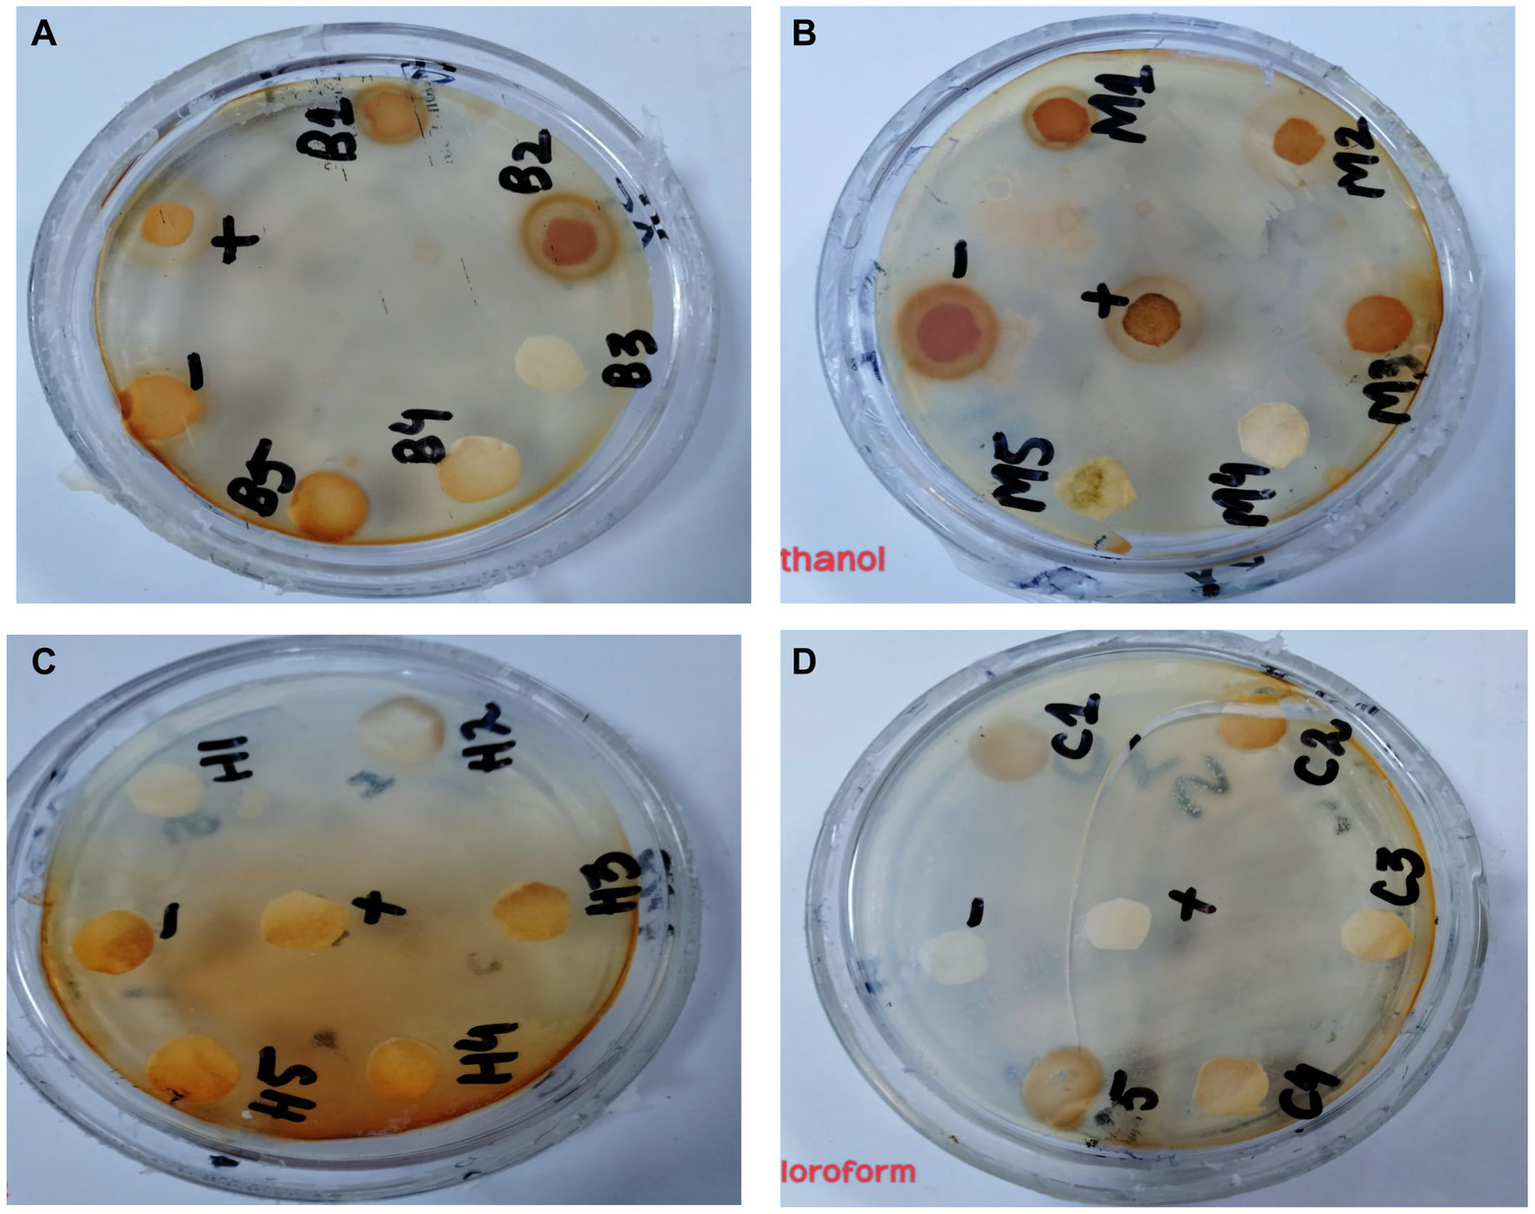
Figure 7

Abstract
Introduction:
Medicinal plants like Punica granatum (pomegranate) have traditional uses against diabetes, inflammation and other diseases. The study was initiated to get an insight into the interaction tendency of P. granatum derived compounds with diabetes associated human thioredoxin-interacting protein (TXNIP). High glucose in diabetes induces production of TXNIP resulting in β-cells apoptosis. Its inhibition might reduce the diabetes incidence.
Methods:
To elucidate the therapeutic potential of P. granatum peel against diabetes through GC-MS based identification of extracted compounds followed by application of computational algorithms. P. granatum peel extracts were screened for antioxidant, anti-inflammatory, anti-diabetic, antimicrobial and wound healing properties. Phytochemical and GC-MS based analysis were performed to identify the bioactive compounds. Molecular docking analysis was performed by Auto Dock Vina to predict the binding tendency of P. granatum derived compounds with TXNIP.
Results and Discussion:
The peel exhibited antioxidant, anti-inflammatory and anti-diabetic activities, which were attributed to phytochemicals like phenols, tannins and steroids. GC-MS analysis identified 3,5-octadien-2-one, 1H-pyrrole -2,5-dione, Beta-D-lyxofuranoside, 5-O-(beta-D-lyxofuranosyl)-decyl, diethyl phthalate, 9-octadecenoic acid (Z)-, methyl ester, hexadecanoic acid, methyl ester, n-hexadecanoic acid, tetradecane, 2,6,10-trimethyl, bis (2-ethylhexyl) phthalate, decane, 3,8-dimethyl, 9-octadecenoic acid (Z)-, methyl ester and bis (2-ethylhexyl) phthalate in P. granatum peel extracts. Docking analysis revealed high binding affinities of bis (2-ethylhexyl) phthalate and 9-octadecenoic acid with TXNIP i.e., –4.5 and –5.0 kcal/mol, respectively, reflecting these compounds as potent antidiabetic agents. This study validates the traditional uses of P. granatum peel and demonstrates how computational approaches can uncover pharmacologically active phytochemicals. The results suggest P. granatum peel is a promising source of novel therapeutics against diabetes, inflammation, and oxidation. Further studies on the optimization of identified ligands are warranted.
Introduction
Plants have been used for centuries in traditional medicines (1). Different diseases can be treated by using traditional techniques. The word pomegranate is derived from “granatus” and “ponus” which are Latin words. The scientific classification of the plant is presented in Table 1. Approximately 1,500,000 tonnes of pomegranate are produced worldwide. Mediterranean-native pomegranate (Punica granatum L.) is used frequently in traditional medicines in several countries, especially throughout the Indian subcontinent. Pomegranate contains approximately 60% peel in its fruit (3). The structure of the plant and peel is shown in Figure 1. It has the ability to perform antifungal, antibacterial, antioxidant, immune-modulatory, anti-atherosclerotic, and anti-bacterial activity (4), as well as having wound healing capacity; cardiovascular diseases, gum bleeds, diabetes, male infertility, eye disorders, infant brain ischemia, and throat issues can be treated with pomegranate plant. It also contains various phytochemical properties. Punicalins, ellagic acid, punicalagins, gallic acid, and gallotannis are the phytochemicals present in the peel. According to reports, the fruit’s peel and juice contain 10–50 mg/100 g and 1–2.38 mg/100 mL of ellagic acid. Numerous bioactive compounds and secondary metabolites such as flavonoids, tannins, phenolic, fibers, vitamins, and minerals, rich in polyphenols and tannins, are present in the peel (1). The non-edible parts including flowers, barks, peel, leaves, and buds play significant roles in the nutritional characteristics, in addition to the fruit’s edible part. Compared to the fruit’s edible portion, the peel is usually known as waste, but it contains biologically active compounds rich in nutrients (5).
Table 1
| Kingdom | Plantae |
|---|---|
| Division | Magnoliophyta |
| Class | Magnoliopsida |
| Subclass | Rosidae |
| Order | Myrtales |
| Family | Lythraceae |
| Genus | Punica |
| Species | P. granatum |
Scientific classification of pomegranate (2).
Figure 1

Punica gramatum plant and peel.
Table 1 shows the scientific classification of pomegranate.
Biological compounds of plant
Pomegranate is rich in bioactive compounds, and they have demonstrated a variety of therapeutic benefits. High concentrations of hydrolyzed ellagitannins known as “pomegranate ellagitannins,” which include pedunculgins, punicalins, and punicalagins, are present in pomegranate, especially in the peel (6). Hexahydroxy diphenic acid and polyol such as glucose or quinin acid are combined to form ellagitannins and are known as esters. The red part of the fruit contains flavonoids (7), which include quercetin, kaempferol, and luteolin. Ellagitannins have hydroxybenzoic acids such as ellagic acid, gallic acid, and ellagic acid glycosides. Anthocyanidins like delphinidin, cyaniding, and pelargonidin, as well as anthocyanins, the pigment responsible for the red color of the pomegranate, are abundant in the arils. The peel contains a significant number of tannins like ellagic acid, pedunculagin, gallic acid, punicalin, and punicalagin; the flavonoids and phenolic chemicals present are catechins and anthocyanins. The most common anthocyanins are cyanidin-3-O-glucoside, cyanidin-3,5-di-O-glucoside, delphinidin-3-O-glucoside, pelargonidin-3-O-glucoside, and pelargonidin-3,5-di-O-gluco. Pomegranate arils also include phenolic acids, such as p-coumaric acid, chlorogenic acid, caffeic acid, ellagic acid, and gallic acid, as well as anthocyanins (8). Phenolic components, which are well recognized for their antioxidant property, are abundant in the peel. Proteins, organic acids, fibers, alkaloids, fatty acids, sugars (maltose, glucose, and fructose), potassium, phosphorus, sodium, calcium, and magnesium are present in the peel. The peel contains high amounts of isopelletierine, pseudopelletierine, pelletierine, and methylpelletierine, as well as alkaloids, succinic, citric, oxalic, and malic acids. It also contains indole amines, α-tocopherols, fatty acids, organic and amino acids, water (85%), pectins (1.4%), and sugar (10.6%) as well as triterpenoids but with a high number of phenols (0.2%–1%). The major groups of phenolic components of pomegranate contain hydrolyzed tannins like punicalagin, gallotanins, and ellagitannins. The fatty acids that are most prevalent in pomegranate seed oil are oleic, linoleic, and punicic acid. The majority of the seed is made up of 80% of punicic acid which is conjugated with 18 carbon fatty acids with triple bonds (9).
Thioredoxin-interacting protein (TXNIP) is an emerging regulator of cellular redox signaling closely intertwined with glucose and energy homeostasis. Over the past two decades, accumulating evidence has strongly established heightened TXNIP activity as a mediator of diabetes pathophysiology (10). TXNIP expression is drastically upregulated by elevated blood glucose levels and promotes insulin resistance through the inhibition of glucose uptake (11). Mechanistically, TXNIP binds with and inhibits the function of thioredoxin (TRX), an endogenous antioxidant factor, leading to a pro-oxidative shift in the intracellular environment (12). This redox imbalance then triggers downstream signaling cascades related to inflammation, gluconeogenesis, apoptosis, and other cell dysfunctions that collectively impair normal uptake and utilization of glucose, thereby worsening. Therefore, the ability of bioactive dietary plant compounds to target and inhibit TXNIP signaling has profound therapeutic implications in diabetes management. Uncovering these nutraceutical resources through innovative methods promises new treatment possibilities as emerging evidence continues to position TXNIP as the central molecular linchpin contributing to insulin resistance over progression to overt diabetes (13).
Biological activities
Determining the antioxidant activity of natural components from flavors and substituting synthetic extracts to prevent the growth of some bacteria and antioxidants is therefore essential (14). Its inner network of membranes comprises almost 26%–30% of the fruit’s weight. Peel and juice compose approximately 92% of fruit antioxidant activity and are abundant sources of such chemicals. The water-soluble polyphenols, quality and safety of products, with preserving their anthocyanins and hydrolyzable tannins, are primarily responsible for this antioxidant capacity, which preservation techniques and to enhance the microbiological property (15).
The isomers of 2,3-(S)-hexahydroxydiphenoyl-4,6-(S,S)-gallagyl-D-glucose that make up the α and β forms of pomegranate punicalagin are polyphenolic hydrolyzed tannins. Pomegranate metabolizes into tiny polyphenol components in the intestinal tract during biological normal conditions because they are hydrophilic in nature (1).
Pomegranate peel showed antibacterial activities against Escherichia coli, Listeria monocytogenes, and Staphylococcus aureus. It has been demonstrated that a dose of 2 mg/disc of peel extract in association with ellagic acid has antimicrobial effects against Streptococcus epidermidis, S. aureus, and Propionibacterium. The peel worked as an antibacterial component when combined with lettuce and parsley before inoculation with E. coli and S. aureus. Similar research was conducted by Abdollahzadeh and partners on the impact of pomegranate methanol extract applied at 4, 8, and 12 mg/mL on the development of dental pathogens. Various tests performed on peel extracts showed effectiveness against Streptococcus salivarius, Streptococcus mutans, and Lactobacillus acidophilus and demonstrated resistance to S. epidermidis and S. aureus. The significant amount of ellagic acids and punicalagins present in extracts are responsible for inhibitory effects against L. monocytogenes through diffusion tests (16).
L. monocytogenes and E. coli showed antibacterial potential, but the peel also acts as a washing agent with hydrosol mint and mint essential oil. L. monocytogenes exhibited more potential than E. coli (17). Antibacterial assay was done through the agar well diffusion method and two types of bacteria were used for antimicrobial assay. Pseudomonas aeruginosa (ATCC 10145) and E. coli (ATCC 11775) were used as gram -ve bacteria while S. aureus (ATCC 6538) and Bacillus subtilis (ATCC 6051) were used as gram +ve bacteria (18). Pomegranate showed minimum inhibitory concentration (MIC) for antibacterial activity against Bacillus cereus and S. aureus. The peel improved the life span of chicken by 2–3 weeks by inhibiting the activity of Pseudomonas at a 0.1% dosage of the peel, but this therapy proved unsuccessful against B. cereus and E. coli. Studies proved that gram -ve and +ve bacteria showed antibacterial activities and the peel was used in the storage of beef. A strong antibacterial activity of films was observed against gram +ve bacteria when the peel was introduced to caseinate-based films (19).
Health benefits
The peel includes hydrolyzable and condensed tannins, anthocyanins, hydroxycinnamic acid, and gallotannins. Punicalin, ellagitannins, and punicalagin are the phenolic compounds present in the peel that have anti-inflammatory, anti-mutagenic, anti-diabetic, antioxidant, wound healing, and antibacterial potential (15). The edible part and peel contain various compounds that have different health benefits. Gallagyl esters, anthocyanins, hydroxybenzoic acids, dihydroflavonol, gallotannins, hydroxycinnamic acids, and ellagitannins are the phenolic compounds in the peel that possess fruit antioxidant activity. Many studies have been published in the literature demonstrating the efficacy of ellagic acid as a treatment for numerous low to mild chronic diseases with extremely slow rates of development. Furthermore, it has proven to be effective for chemoprevention of cancer (20). Ellagic acid has been shown to reduce the production of triglycerides and white fat accumulation, which is a result of regular consumption of a high-fat diet, in addition to another of its ethno-pharmacological characteristics. The previous research found that oxidative damage, living cells, and reduction of sulfhydryl pool (non-protein) can be protected by the cytoprotective properties of the peel. The antioxidant activity of the peel is positively correlated with higher ellagic acid concentrations. The peel can also be used as a washing agent. NaOCl therapies and pomegranate extracts are used for cleaning fresh vegetables (21).
Cell damage is caused by the reaction of free radicals with carbohydrates, human DNA, lipids, and proteins because free radicals are highly unstable and volatile in nature (22). Free radicals react with macromolecules to promote carcinogenesis, nucleic acid oxidation, lipid peroxidation, and cardiovascular disorders. So, to prevent negative effects on human organs, tissues, and cells, antioxidants are used to inhibit the spontaneous free radical reaction (23). As an antioxidant-rich fruit, pomegranates can considerably and pleasantly impact people’s health. In addition to studies identifying phytochemicals present in pomegranate culture, the historical importance stimulates the research and evaluation of the anti-bacterial, anti-diabetic, and antioxidant properties of peel (24). Most food products need to be protected from phenolic antioxidants; during its shelf life, the peel is known to develop bacterial decomposition (25). With an increased consumer demand for safe herbal treatments with anti-bacterial, anti-atherosclerotic, anti-cancer, and wound healing capacities, researchers should thoroughly investigate the efficacy of the moderate antioxidant ability of pomegranate peel (15).
The bioactive compounds of the peel have shown antioxidant, antimicrobial, antidiabetic, and anti-inflammatory properties in various research, indicating their therapeutic effects in different diseases such as ethanol-acetone ulceration, gastro-mucosal injuries, diabetic oxidative damage, and leukemia chemoprevention. Precipitation of membrane proteins that results in microbial cell death is the mechanism through which peel phenolics exhibit their antibacterial effect. Peel anti-mutagenic and antibacterial characteristics are part of its ethno-medicinal profile that makes its traditional value. Furthermore, phytochemicals present in the peel are effective without adding extracts from any other fruit components (26). The pomegranate fruit and its derivatives may contain medicinal value with significant phytochemicals and secondary metabolites, according to previous research. Oxidative food stability can be maintained by using peel extract. Litopenaeus vannamei is prevented using peel extract in methanol as it works like a natural preservative. Two doses of peel extracts of 10 or 20 g significantly inhibit the growth of Enterobacteriaceae, psychrophilic, mesophilic, and lactic acid bacteria (LAB) in white shrimps. Pomegranate peel stabilizes shrimp quality and is used to decrease thiobarbituric, trimethylamine, and total volatile basic nitrogen. It is used to preserve Kalari cheese in India. The peel inhibits the production of coliform during preservation because fungus, yeast, and psychrophilic quantities are inhibited by peel extracts. The aims and objectives of the research include the preparation of extracts in different solvents such as methanol, chloroform butanol, and n-hexane. Phytochemical identification was done and gas chromatography-mass spectrometry (GC-MS) analysis of extracts was performed. The biological activities of the peel were determined. In silico studies were performed to design drugs against diabetes (8).
Materials and methods
Pomegranate fruits were obtained from local markets and peels were separated, cut, dried at room temperature, and powdered using a commercial grinder. For each prepared extract, 50 g of pomegranate peel powder was soaked in 500 mL of solvent (methanol, butanol, n-hexane, or chloroform) for 10 days at room temperature. The extracts were then filtered, and the filtrates were dried first using a rotary evaporator at 45°C followed by a drying oven to remove any remaining solvent. This yielded dried methanolic, butanolic, hexanic, and chloroform pomegranate peel extracts for subsequent phytochemical analysis and bioactivity testing experiments (see Table 2).
Table 2
| Sr. | Tests | Plant extracts | |||
|---|---|---|---|---|---|
| Methanol | Butanol | n-hexane | Chloroform | ||
| 1. | Phenols | + | − | + | − |
| 2. | Flavonoids | + | + | − | + |
| 3. | Glycosides | + | + | − | + |
| 4. | Tannins | + | + | + | − |
| 5. | Terpenoids | + | + | − | + |
| 6. | Steroids | + | − | + | − |
| 7. | Saponins | − | + | + | − |
Phytochemical screening of P. granatum peel.
Phytochemical screening of extracts
Test for phenols
A pinch of FeCl3 and 3 mL ethanol were added to 2 mL of extract. Phenols were confirmed by the appearance of greenish-yellow coloration (27).
Test for flavonoids
One milliliter of each extract was added into the test tube then 1 mL of 10% NaOH was added. The presence of flavonoids was confirmed by the appearance of yellow to orange color.
Test for tannins
One milliliter of each extract was added to different test tubes then 1 mL of FeCl3 was added. The presence of tannins was confirmed by the appearance of blue to green color.
Test for saponins
Distilled water (20 mL) was added to 2 mL of sample in a test tube and shaken for 15 min.
Layers of 1 cm foam appeared and saponins were indicated.
Test for terpenoids
In the test tubes, 2 mL of each extract and 3 mL of conc were added. H2SO4 was added along the wall of the test tube. Then, 2 mL of chloroform was added and there was the formation of single reddish-brown layers appeared and the presence of terpenoids was confirmed.
Test for glycosides
In each test tube, 0.5 mg of each extract was added to 1 mL of distilled water and 1 mL of aqueous NaOH was added (Figure 2). Glycosides were confirmed by the formation of a yellow color (28).
Figure 2

Phytochemical screening of P. granatum peel extract [M (methanol), B (butanol), H (n-hexane), and C (chloroform)].
Biological activities of Punica granatum
DPPH radical scavenging activity
DPPH radical scavenging assay was carried out to evaluate antioxidant potential. A 0.5 mg/mL DPPH solution was prepared in ethanol. Different concentrations of the pomegranate peel extract (0.5, 0.25, 0.125, 0.0625, and 0.03125 mg/mL) were prepared in DMSO. In an ELISA plate protected from light, 100 μL DPPH solution was mixed with an equal volume of the extract solutions and incubated at 37°C for 35 min. DMSO solution served as the control. Absorbance was measured at 630 nm. Standard ascorbic acid solutions were processed in parallel for comparison along with a negative control lacking extract. All experimental and standard conditions were performed in triplicates. Decreased absorbance indicated free radical scavenging through hydrogen donation and the antioxidant capacity of extracts. The IC50 values denoted effective concentrations of extract displaying 50% radical inhibition (28).
The formula used to calculate the radical scavenging percentage is:
Anti-inflammatory activity
The anti-inflammatory activity of P. granatum extract and its fractions was assessed using the method described with modifications. For the preparation of bovine serum albumin protein solution, 200 mg BSA was dissolved in 20 mL distilled water. Twenty Eppendorf were taken in which 100 μL of each concentration solution of extract (0.5, 0.25, 0.125, 0.0625, and 0.03125 mg/mL) was taken; then in all Eppendorf, 100 μL BSA solution was added. After this, they were heated in a water bath for some time at 70°C. A measurement of 100 μL of mixture solution was then added to an ELISA plate and its absorbance was measured at a wavelength of 630 nm. A dicloran concentration of 0.1 mg/mL was taken as the positive control and distilled water as the negative control. Triplicate values were taken. The formula used to calculate the inhibition percentage (28) is:
Anti-diabetic activity
The anti-diabetic activity was assessed by α-glucosidase assay. Phosphate buffer with 0.07 M molarity and 6.8 pH was prepared with p-NPG substrate, α-glucosidase enzyme (2.0 U m/L), and α-glucosidase (2.5 U m/L). In the ELISA plate, 70 μL of buffer was added in the wells and then incubated for 5 min. After that, 10 μL of extracts and 10 μL of enzymes were added to each well. Substrate of 10 μL was added and re-incubated for 30 min. After that, 80 μL of Na2CO3 was added as a negative control to stop the reaction. Acarbose was used as a positive control. Then anti-diabetic potential against α-glucosidase was measured using ELISA at 405 nm (29). Results were obtained using the following formula:
Antibacterial activity
Antibacterial assay of P. granatum samples was performed by the disc diffusion method. Both gram -ve and gram +ve bacterial strains were used to find out the antibacterial activity. Staphylococcus viridans strain was used as gram +ve and E. coli strain was used as gram -ve.
Preparation of culture
We used nutrient broth for the culture preparation. One gram of NaCl, 1 g of pet one, and 0.5 g of yeast were dissolved in 100 mL of distilled water. After proper mixing, a yellow color was formed and the nutrient broth was autoclaved. Then, the nutrient broth was equally poured into three conical flasks after cooling (25°C). One colony of bacteria was picked using a sterile loop and transferred into falcon tubes; all experiments were performed in laminar flow. The broth was placed in a shaking incubator (37°C) for 24 h. After 24 h, faint turbidity appeared and the culture was prepared.
Preparation of plates
Preparation of plates was done using 2 g of NaCl, 2 g of peptone, 1 g of yeast, and 4 g of agar dissolved in 200 mL of distilled water. Then, the material and plates were autoclaved to avoid contamination. After that, the experiment was performed in laminar flow. Plates were poured and kept for a while for solidification.
Spreading
The culture was picked up with cotton buds and then spread on plates.
Disc diffusion method
The antibacterial activity of four extracts of P. granatum was investigated by the disc diffusion method. Bacterial strains were used for this purpose. Strains were picked up and spread on agar plates. Whatman filter paper with 11 μm pore size was dipped in the media plates with 200 mg/mL of extract concentration. Then, the plates were kept in an incubator for 24 h at 37°C by covering properly with paraffin. DMSO solution (10%) was used as a negative control and ciprofloxacin was used as a positive control. Then, after 24 h, plates were checked and the zone was measured in mm (30).
Drug designing against diabetes
Protein structure retrieval from Protein Data Bank
A Protein Data Bank is a database that contains a large number of protein sequences, structures, and functions. The 3D structure of the required protein, i.e., thioredoxin interaction protein, was retrieved from PDB. The selected protein PDB ID is 1-TRW (31).
Ligand structure retrieval from PubChem
The National Center of Biotechnology Information (NCBI) has established a PubChem server for ligand retrieval. Some other servers that can also be used for ligand retrieval are ZINC and ChEMBL. Ligands were downloaded as a 3D SDF file and different ligands were taken from PubChem (32).
Preparation of ligand and protein by Discovery Studio Visualizer
Discovery Studio Visualizer was used for the preparation of protein and ligands. For the ligand and protein purification, water molecules were removed and the file was saved from the SDF to the PDB file. So, purified protein and ligand were obtained (33).
Molecular docking of ligand and protein
AutoDock Vina is the most used software for checking the interaction between proteins and ligands with each other. It provides a complex structure with complete interaction of ligand to protein. First, the purified structure of protein is opened in AutoDock Vina then the grid is set out with dimensions and a torsion tree. Then, the command is run and energies of different values are taken (34) (see Figure 2).
Results
Qualitative analysis of Punica granatum
Phytochemical analysis showed that phenols were present in methanol and n-hexane extracts while other extracts showed negative results. Flavonoids were present in all extracts except in n-hexane. All extracts contained glycosides except n-hexane. Tannins were present in methanol, butanol, and n-hexane but not in chloroform extract. Terpenoids were present in all extracts but not in n-hexane extracts. Steroids only showed in methanol and n-hexane extracts. Saponins were present in butanol and n-hexane extracts but were not present in methanol and chloroform extracts.
Quantitative analysis of methanol and n-hexane extract through gas chromatography-mass spectrometry
Gas chromatography connected with mass spectroscopy was used to determine the methanolic extract of P. granatum peel. It shows many compounds that have antioxidant, anti-diabetic, and anti-inflammatory properties. The highest-placed compounds were examined by GC-MS. GC-MS spectrum showed the 43 compounds with their chemical structure, retention time, and area. The identification of compounds is shown in Figure 3.
Figure 3

GC-MS chromatogram of methanol extract of P. granatum. Methanolic extracts have 43 compounds, and retention time, peaks, and peak area were determined by GC-MS.
The compounds that have been identified in methanol extract, their names, formulas, molecular weight, and retention time are presented in Table 3.
Table 3
| Sr. | Compound name | Mol. formula | Mol. weight (g/mol) | Retention time (mint) |
|---|---|---|---|---|
| 1. | Thymine | C5H6N2O2 | 126.11 | 4.259 |
| 2. | 3,5-octadien-2-one | C8H12O | 124.18 | 4.377 |
| 3. | 4H-Pyran-4-one, 2,3-dihydro-3,5-dihydroxy-6-methyl | C6H8O4 | 144.12 | 5.090 |
| 4. | 1H-pyrrole-2,5-dione | C4H3NO2 | 97.07 | 6.118 |
| 6. | n-propylcyclopropanemethylamine | C7H15N | 113.20 | 8.020 |
| 7. | Trisiloxane, 1,1,1,5,5,5-hexamethyl-3,3-bis[(trimethylsilyl)oxy]- | C12H36O4Si5 | 384.84 | 8.963 |
| 8. | Beta-D-lyxofuranoside, 5-O-(beta-D-lyxofuranosyl)-decyl | C20H38O9 | 422.5 | 9.029 |
| 10. | Butylated hydroxytoluene | C15H24O | 220.35 | 9.586 |
| 11. | Diethyl phthalate | C12H14O4 | 222.24 | 10.606 |
| 12. | Benzeneethanamine, N-[(pentafluorophenyl)methylene]-beta.,3,4-tris[(trimethylsilyl)oxy]- | C24H34F5NO3Si3 | 563.8 | 10.907 |
| 13. | (S)-(-)-1,1′-Bi-2-naphthol, O,O′-bis(trimethylsilyl) | C26H30O2Si2 | 430.7 | 12.597 |
| 14. | 2-(2′,4′,4′,6′,6′,8′,8′-Heptamethyltetrasiloxan-2′-yloxy)-2,4,4,6,6,8,8,10,10-nonamethylcyclopentasiloxane | C16H48O10Si9 | 653.3 | 14.103 |
| 15. | Hexadecanoic acid, methyl ester | C17H34O2 | 270.5 | 14.210 |
| 16. | n-hexadecanoic acid | C16H32O2 | 256.42 | 14.593 |
| 17. | Hexasiloxane, tetradecamethyl | C14H42O5Si6 | 458.99 | 15.480 |
| 18. | 9,12-octadecadienoic acid (Z,Z)-, methyl ester | C19H34O2 | 294.5 | 15.850 |
| 19. | 9-octadecenoic acid (Z)-, methyl ester | C19H36O2 | 296.5 | 15.909 |
| 20. | Heptadecanoic acid, 16-methyl-, methyl ester | C19H38O2 | 298.5 | 16.142 |
| 21. | Octadecanoic acid | C18H36O2 | 284.5 | 16.498 |
| 22. | Hexasiloxane, tetradecamethyl | C14H42O5Si6 | 458.99 | 16.727 |
| 23. | Trisiloxane, 1,1,1,5,5,5-hexamethyl-3,3-bis[(trimethylsilyl)oxy] | C12H36O4Si5 | 384.84 | 18.968 |
| 24. | Oxalic acid, 2-ethylhexyl tetradecyl ester | C24H46O4 | 398.6 | 19.319 |
| 25. | Bis(2-ethylhexyl) phthalate | C24H38O4 | 390.6 | 19.595 |
| 26. | Octasiloxane, 1,1,3,3,5,5,7,7,9,9,11,11,13,13,15,15-hexadecamethyl | C16H48O7Si8 | 577.2 | 20.958 |
| 27. | Tetrasiloxane, decamethyl | C10H30O3Si4 | 310.68 | 22.707 |
| 28. | Methyltris(trimethylsiloxy)silane | C10H30O3Si4 | 310.68 | 23.512 |
Compounds identified in methanol extract by GC-MS.
GC-MS analysis of n-hexane
Gas chromatography connected with mass spectroscopy was used to determine the methanolic extract of P. granatum peel. It was used to determine many compounds that have antioxidant, anti-diabetic, and anti-inflammatory properties. The highest-placed compounds were examined by GC-MS. GC-MS spectrum showed the 42 compounds with their chemical structure, retention time, and area. Octasiloxane, 1,1,3,3,5,5,7,7,9,9,11,11,13,13,15,15-hexadecamethyl, butylated hydroxytoluene, n-hexadecanoic acid, 9,12-octadecadienoic acid (Z,Z), Carbonic acid, dodecyl 2-ethylhexyl ester, cis-9-hexadecenoic acid, tetradecanoic acid, and 2-Heptenoic acid were obtained with highest peaks. The identified compounds are presented in Figure 4.
Figure 4

GC-MS chromatogram of n-hexane extract of P. granatum. n-hexane extract has 42 compounds, and retention time, peaks, and peak area were determined by the GC-MS.
The compounds identified in n-hexane extract, their compound names, formulas, molecular weight, and retention time are shown in Table 4.
Table 4
| Sr. | Compound name | Mol. formula | Mol. Weight (g/mol) | Retention time (mint) |
|---|---|---|---|---|
| 1. | Octasiloxane, 1,1,3,3,5,5,7,7,9,9,11,11,13,13,15,15-hexadecamethyl | C16H48O7Si8 | 577.2 | 8.965 |
| 2. | 2,6-Di-tert-butyl-4-hydroxy-4-methylcyclohexa-2,5-dien-1-one | C15H24O2 | 236.35 | 9.031 |
| 3. | Butylated hydroxytoluene | C15H24O | 220.35 | 9.590 |
| 4. | Benzeneethanamine, N-[(pentafluorophenyl)methylene]-.beta.,3,4-tris[(trimethylsilyl)oxy] | C24H34F5NO3Si3 | 563.8 | 10.909 |
| 5. | 7,9-Di-tert-butyl-1-oxaspiro(4,5)deca-6,9-diene-2,8-dione | C17H24O3 | 276.4 | 14.080 |
| 6. | Hexadecanoic acid, methyl ester | C17H34O2 | 270.5 | 14.214 |
| 7. | 1,4-Dibutyl benzene-1,4-dicarboxylate | C16H22O4 | 278.34 | 14.559 |
| 8. | n-hexadecanoic acid | C16H32O2 | 256.42 | 14.609 |
| 9. | Cyclohexadecane | C16H32 | 224.42 | 15.913 |
| 11. | 1,1,1,5,7,7,7-heptamethyl-3,3-bis(trimethylsiloxy)tetrasiloxane | C13H39O5Si6 | 443.96 | 16.730 |
| 12. | Decane, 3,8-dimethyl | C9H14N2O3 | 198.22 | 16.808 |
| 14. | Octasiloxane, 1,1,3,3,5,5,7,7,9,9,11,11,13,13,15,15-hexadecamethyl | C16H48O7Si8 | 577.2 | 17.882 |
| 17. | Carbonic acid, dodecyl 2-ethylhexyl ester | C21H42O3 | 342.6 | 19.329 |
| 18. | Bis(2-ethylhexyl) phthalate | C24H38O4 | 390.6 | 19.611 |
| 19. | Methyltris(trimethylsiloxy)silane | C10H30O3Si4 | 310.68 | 19.996 |
| 20. | Tetradecane, 2,6,10-trimethyl | C17H36 | 240.5 | 20.101 |
| 21. | Arsenous acid, tris(trimethylsilyl) ester | C9H27AsO3Si3 | 342.49 | 20.422 |
| 22. | Arsenous acid, tris(trimethylsilyl) ester | C9H27AsO3Si3 | 342.49 | 20.531 |
| 23. | Methyltris(trimethylsiloxy)silane | C10H30O3Si4 | 310.68 | 20.850 |
| 24. | 4-(4-Hydroxyphenyl)-4-methyl-2-pentanone | C15H24O2Si | 264.43 | 20.958 |
| 28. | Tetrasiloxane, decamethyl | C10H30O3Si4 | 310.68 | 21.860 |
| 29. | Cyclotrisiloxane, hexamethyl | C6H18O3Si3 | 222.46 | 22.274 |
| 31. | 1,2-bis(trimethylsilyl)benzene | C12H22Si2 | 222.47 | 22.954 |
| 32. | Methyltris(trimethylsiloxy)silane | C10H30O3Si4 | 310.68 | 23.090 |
| 33. | Arsenous acid, tris(trimethylsilyl) ester | C9H27AsO3Si3 | 342.49 | 23.252 |
| 34. | Arsenous acid, tris(trimethylsilyl) ester | C9H27AsO3Si3 | 342.49 | 23.402 |
| 36. | 4-(7-methyloctyl)phenol | C15H24O | 220.35 | 23.512 |
| 39. | 2,4,6-cycloheptatrien-1-one, 3,5-bis-trimethylsilyl | C13H22OSi2 | 250.48 | 23.874 |
| 40. | Tetrasiloxane, decamethyl | C10H30O3Si4 | 310.68 | 23.911 |
| 41. | 4-(4-hydroxy-2,5-dimethylbenzyl)morpholine, TMS | 24.134 | ||
| 42. | Arsenous acid, tris(trimethylsilyl) ester | C9H27AsO3Si3 | 342.49 | 24.286 |
Compounds identified in n-hexane extract by GC-MS.
Biological activities of Punica granatum
Antioxidant activity
The antioxidant potential of P. granatum and its fractions was determined using the DPPH radical scavenging assay. Radical scavenging activity was evaluated at different concentrations of fractions. Results were analyzed statistically. Methanol, chloroform, n-hexane, and butanol showed antioxidant potential at 0.5 mg/mL concentrations of 85 ± 0.096, 71 ± 0.029, 65 ± 0.050, and 89 ± 0.019, respectively. When concentration decreased, then antioxidant potential also decreased to 80 ± 0.029, 60 ± 0.025, 58 ± 0.049, and 86.6 ± 0.023 for methanol, chloroform, n-hexane, and butanol concentration, respectively. Butanol and methanol fractions showed the highest antioxidant activity. The order of antioxidant activity results was butanol > methanol > chloroform > n-hexane. Results are shown in Figure 5. Ascorbic acid was taken as standard which showed radical scavenging percentage at different concentrations, i.e., 0.5, 0.25, 0.125, 0.0625, and 0.03125 mg/mL as 98.9 ± 0.007, 98.5 ± 0.005, 97.3 ± 0.012, 96.6 ± 0.015, and 96 ± 0.014, respectively.
Figure 5

Antioxidant activity of P. granatum extracts.
The antioxidant activity of peel has been shown by different extracts. The highest activity was shown by butanol and methanol extract which are 89 ± 0.019 and 85 ± 0.096, respectively, as shown in Figure 5.
Anti-inflammatory activity
Results showed that fractions at concentrations of 0.5 mg/mL extracts such as methanol, chloroform, n-hexane, and butanol showed anti-inflammatory activity at 90 ± 0.034, 66 ± 0.017, 77 ± 0.060, and 78 ± 0.017, respectively. When concentration decreased, inhibition values also decreased. At 0.25 mg/mL, inhibition decreased at 86 ± 0.016, 60 ± 0.020, 75 ± 0.045, and 72 ± 0.009, respectively according to fractions. Dicloran was taken as standard which showed its maximum inhibition at 98 ± 0.005, 97.8 ± 0.015, 96.6 ± 0.018, 95 ± 0.019, and 94 ± 0.012 at different concentrations of 0.5, 0.25, 0.125, 0.625, and 0.03125 mg/mL, so dicloran exhibited inhibition percentages of 98%, 97.8%, 96.6%, 95%, and 94%. Results are presented in Figure 6.
Figure 6

% age inhibition of P. grantum extracts.
The anti-inflammatory activity of the plant has been shown in different extracts at different concentrations. The highest activity was shown by methanol and butanol at 90 ± 0.034 and 78 ± 0.017, respectively, and results are shown in Figure 6.
Antibacterial activity
In the antibacterial assay, S. viridans was used as gram +ve and E. coli as gram -ve bacterial strains. Extracts of methanol and butanol showed resistance against gram +ve bacteria. Peel extract of methanol and butanol showed antibacterial activity against S. viridans. The zone of inhibition has been measured in mm for different extracts of P. granatum peel, as shown in Table 5. The zones shown in Figure 7 are for S. viridans. The non-resistant bacteria were E. coli whose results are shown in Figure 8.
Table 5
| Sr. | Bacterial strains | Extracts | Concentration (mg/mL) | Mean ± S.D. |
|---|---|---|---|---|
| 1. | Staphylococcus viridans | Methanol | 0.5 | 15 ± 0.34 |
| 0.25 | 7 ± 0.15 | |||
| 0.125 | 12 ± 0.26 | |||
| 0.0625 | 10 ± 0.22 | |||
| 0.03125 | 13 ± 0.29 | |||
| Butanol | 0.5 | 16 ± 0.39 | ||
| 0.25 | 10 ± 0.22 | |||
| 0.125 | 12 ± 0.26 | |||
| 0.0625 | 8 ± 0.16 | |||
| 0.03125 | 6 ± 0.14 | |||
| n-hexane | 0.5 | 0 | ||
| 0.25 | 2 ± 0.06 | |||
| 0.125 | 3 ± 0.09 | |||
| 0.0625 | 8 ± 0.16 | |||
| 0.03125 | 0 | |||
| Chloroform | 0.5 | 10 ± 0.22 | ||
| 0.25 | 0 | |||
| 0.125 | 0 | |||
| 0.0625 | 0 | |||
| 0.03125 | 12 ± 0.26 | |||
| Ampicillin | +ve control | 16 ± 0.39 | ||
| 10% DMSO | −ve control | 0 | ||
| 2. | E. coli | Methanol | 0.5 | 8 ± 0.16 |
| 0.25 | 10 ± 0.22 | |||
| 0.125 | 6 ± 0.14 | |||
| 0.0625 | 7 ± 0.15 | |||
| 0.03125 | 3 ± 0.09 | |||
| Butanol | 0.5 | 10 ± 0.22 | ||
| 0.25 | 6 ± 0.14 | |||
| 0.125 | 9 ± 0.20 | |||
| 0.0625 | 8 ± 0.16 | |||
| 0.03125 | 3 ± 0.09 | |||
| n-hexane | 0.5 | 0 | ||
| 0.25 | 0 | |||
| 0.125 | 0 | |||
| 0.0625 | 0 | |||
| 0.03125 | 0 | |||
| Chloroform | 0.5 | 0 | ||
| 0.25 | 0 | |||
| 0.125 | 0 | |||
| 0.0625 | 0 | |||
| 0.03125 | 0 | |||
| Ampicillin | +ve control | 0 | ||
| 10% DMSO | −ve control | 0 |
Antibiotics resistance against various resistant and non-resistant bacteria.
Figure 7
Antibacterial effect of extracts against resistant bacteria S. viridans(A) butanol, (B) methanol, (C)n-hexane, and (D) chloroform.
Figure 8

Non-resistant bacteria E. coli(A) methanol, (B) butanol, (C)n-hexane, and (D) chloroform.
Anti-diabetic activity
Anti-diabetic activity was done using ELISA. The highest activity was observed in methanol, and butanol showed the lowest activity. The greatest activity was exhibited by methanol and butanol extracts. Determination of IC50 of methanol and butanol extracts is shown in Figures 9–11.
Figure 9

Determination of IC50 of methanol extract.
Figure 10

Determination of IC50 of butanol extract.
Figure 11

Graphical representation of anti-diabetic results of P. granatum.
The percentage concentration of extracts is shown in Table 6. The highest percentage of methanol extract is 80.5%.
Table 6
| Mode | Binding affinity (kcal/mol) | Distance from the best mode | |
|---|---|---|---|
| (rmsd 1.b.) | (rmsd u.b.) | ||
| Binding affinity of 3,5-octadien-2-one with TXNIP | |||
| 1 | −3.9 | 0.000 | 0.000 |
| 2 | −3.8 | 18.621 | 19.601 |
| 3 | −3.8 | 2.839 | 3.220 |
| 4 | −3.7 | 3.181 | 5.382 |
| 5 | −3.7 | 23.481 | 24.945 |
| 6 | −3.6 | 14.582 | 15.811 |
| 7 | −3.5 | 3.641 | 5.815 |
| 8 | −3.4 | 4.053 | 4.850 |
| Binding affinity of 1H-pyrrole -2,5-dione with TXNIP | |||
| 1 | −3.9 | 0.000 | 0.000 |
| 2 | −3.6 | 15.542 | 15.954 |
| 3 | −3.6 | 15.541 | 16.167 |
| 4 | −3.6 | 16.911 | 17.284 |
| 5 | −3.6 | 1.864 | 2.169 |
| 6 | −3.5 | 15.321 | 15.593 |
| 7 | −3.4 | 15.345 | 15.890 |
| 8 | −3.4 | 15.515 | 16.114 |
| 9 | −3.4 | 18.617 | 18.985 |
| Binding affinity of 1H-pyrrole -2,5-dione beta-D-lyxofuranoside, 5-O-(beta-D-lyxofuranosyl)-decyl with TXNIP | |||
| 1 | −4.4 | 0.000 | 0.000 |
| 2 | −4.3 | 17.474 | 20.481 |
| 3 | −4.2 | 16.557 | 18.937 |
| 4 | −4.2 | 1.458 | 4.922 |
| 5 | −4.0 | 1.590 | 3.029 |
| 6 | −3.9 | 19.676 | 23.532 |
| 7 | −3.9 | 1.410 | 4.955 |
| 8 | −3.7 | 24.814 | 28.370 |
| 9 | −3.6 | 1.257 | 2.171 |
| Binding affinity of diethyl phthalate with TXNIP | |||
| 1 | −4.2 | 0.000 | 0.000 |
| 2 | −4.2 | 26.476 | 30.028 |
| 3 | −4.2 | 1.757 | 3.085 |
| 4 | −4.1 | 4.055 | 7.863 |
| 5 | −4.1 | 1.584 | 2.253 |
| 6 | −4.0 | 1.471 | 2.514 |
| 7 | −3.9 | 11.158 | 13.499 |
| 8 | −3.8 | 22.068 | 23.333 |
| 9 | −3.7 | 1.557 | 3.513 |
| Binding affinity of 9-octadecenoic acid (Z)-, methyl ester | |||
| 1 | −4.5 | 0.000 | 0.000 |
| 2 | −4.4 | 20.879 | 23.520 |
| 3 | −4.4 | 20.350 | 23.271 |
| 4 | −4.4 | 20.224 | 23.951 |
| 5 | −4.4 | 20.326 | 23.145 |
| 6 | −4.3 | 19.659 | 22.878 |
| 7 | −4.3 | 20.154 | 23.001 |
| 8 | −4.3 | 5.542 | 8.583 |
| 9 | −4.2 | 18.811 | 23.100 |
| Binding affinity of hexadecanoic acid, methyl ester | |||
| 1 | −4.1 | 0.000 | 0.000 |
| 2 | −3.8 | 17.548 | 19.890 |
| 3 | −3.7 | 16.591 | 19.286 |
| 4 | −3.6 | 26.541 | 28.701 |
| 5 | −3.6 | 1.712 | 1.958 |
| 6 | −3.5 | 3.957 | 7.771 |
| 7 | −3.5 | 21.723 | 24.733 |
| 8 | −3.4 | 16.952 | 19.951 |
| 9 | −3.4 | 3.886 | 8.056 |
| Energies of TXNIP with 9-octadecenoic acid (Z)-, methyl ester | |||
| 1 | −4.5 | 0.000 | 0.000 |
| 2 | −4.4 | 20.879 | 23.520 |
| 3 | −4.4 | 20.350 | 23.271 |
| 4 | −4.4 | 20.224 | 22.951 |
| 5 | −4.4 | 20.326 | 23.145 |
| 6 | −4.3 | 19.659 | 22.878 |
| 7 | −4.3 | 20.154 | 23.001 |
| 8 | −4.3 | 5.542 | 8.583 |
| 9 | −4.2 | 18.811 | 23.100 |
| Energies of TXNIP with hexadecanoic acid, methyl ester | |||
| 1 | −4.1 | 0.000 | 0.000 |
| 2 | −3.8 | 17.548 | 19.890 |
| 3 | −3.7 | 16.591 | 19.286 |
| 4 | −3.6 | 26.541 | 28.701 |
| 5 | −3.6 | 1.712 | 1.958 |
| 6 | −3.5 | 3.957 | 7.771 |
| 7 | −3.5 | 21.723 | 24.733 |
| 8 | −3.4 | 16.952 | 19.951 |
| 9 | −3.4 | 3.886 | 8.056 |
| Energies of TXNIP with n-hexadecanoic acid | |||
| 1 | −4.5 | 0.000 | 0.000 |
| 2 | −4.4 | 20.003 | 22.424 |
| 3 | −4.2 | 1.604 | 2.535 |
| 4 | −4.0 | 19.607 | 20.856 |
| 5 | −4.0 | 21.531 | 22.971 |
| 6 | −4.0 | 25.287 | 26.224 |
| 7 | −4.0 | 24.777 | 26.230 |
| 8 | −3.9 | 25.253 | 26.260 |
| 9 | −3.9 | 18.834 | 19.952 |
| Energies of TXNIP with tetradecane, 2,6,10-trimethyl | |||
| 1 | −4.5 | 0.000 | 0.000 |
| 2 | −4.3 | 22.755 | 25.716 |
| 3 | −4.3 | 2.085 | 6.502 |
| 4 | −4.2 | 22.799 | 25.683 |
| 5 | −4.2 | 17.737 | 19.172 |
| 6 | −4.2 | 1.189 | 3.400 |
| 7 | −4.0 | 17.879 | 19.791 |
| 8 | −4.0 | 1.548 | 2.634 |
| 9 | −3.9 | 17.927 | 19.445 |
| Energies of TXNIP with bis (2-ethylhexyl) phthalate | |||
| 1 | −5.0 | 0.000 | 0.000 |
| 2 | −4.8 | 26.261 | 29.495 |
| 3 | −4.8 | 25.759 | 29.424 |
| 4 | −4.8 | 25.607 | 29.561 |
| 5 | −4.8 | 1.108 | 2.489 |
| 6 | −4.7 | 25.485 | 29.490 |
| 7 | −4.7 | 1.350 | 7.700 |
| 8 | −4.6 | 25.134 | 28.838 |
| 9 | −4.6 | 1.739 | 3.010 |
| Energies of TXNIP with decane, 3,8-dimethyl | |||
| 1 | −4.0 | 0.000 | 0.000 |
| 2 | −3.8 | 17.829 | 19.803 |
| 3 | −3.8 | 1.674 | 3.031 |
| 4 | −3.7 | 1.720 | 3.959 |
| 5 | −3.7 | 17.763 | 19.245 |
| 6 | −3.6 | 2.831 | 4.993 |
| 7 | −3.5 | 2.533 | 5.213 |
| 8 | −3.4 | 16.354 | 18.655 |
| 9 | −3.4 | 17.728 | 19.545 |
Energies of TXNIP protein with 3,5-octadien-2-one.
In silico analysis
Docking analysis was performed by making proteins, that is, thioredoxin interaction protein (TXNIP), to interact with different ligands identified from the GC-MS analysis of methanol and n-hexane extracts. The 3D structure of the protein was retrieved from a protein data bank (PDB).
In silico docking analysis of methanol-identified compounds
In silico analysis was performed using AutoDock Vina, which is an offline tool providing the interaction of protein with ligands. Protein and ligand interaction was observed. Docking was performed for the identification of interaction between both of these. Different ligands interacted with protein and few of them showed the highest interaction in the form of energies (Table 6). The docked structure of TXNIP with different ligands is shown in Figures 12, 13.
Figure 12

Interaction of TXNIP proteins with different metabolites extracted from P. granatum predicted using AutoDock Vina. (A) 3,5-octadien-2-one, (B) 1H-pyrrole -2,5-dione, (C) beta-D-lyxofuranoside, 5-O-(beta-D-lyxofuranosyl)-decyl, (D) diethyl phthalate, (E) 9-octadecenoic acid (Z)-, methyl ester, (F) hexadecanoic acid, methyl ester, (G)n-hexadecanoic acid, (H) tetradecane, 2,6,10-trimethyl, (I) bis (2-ethylhexyl) phthalate, and (J) decane, 3,8-dimethyl.
Figure 13

Interaction of (A) 9-octadecenoic acid (Z)-, methyl ester with TXNIP from methanol extract and with (B) bis (2-ethylhexyl) phthalate from n-hexane extract.
The interaction of protein was checked through AutoDock Vina using different ligands identified from methanol and n-hexane extracts through GC-MS. Various interactions were checked out with TXNIP in methanol extract, and the highest interactions were observed by 9-octadecenoic acid (Z)-, methyl ester from methanol and bis (2-ethylhexyl) phthalate from n-hexane extract, with energy values of −4.5 and −5.0 kcal/mol, respectively.
Discussion
It is well recognized that plants are a source of chemicals for the creation of novel medications. Pomegranate contains approximately 60% peel in its fruit. Punicalins, ellagic acid, punicalagins, gallic acid, and gallotannis are the phytochemicals present in pomegranate peel. The non-edible parts including flowers, barks, peel, leaves, and buds play significant roles in nutritional characteristics in addition to the fruit’s edible part. Compared to the fruit’s edible portion, the peel is usually known as waste but it contains biologically active compounds rich in nutrients, so the peel has more therapeutic benefits. Due to a number of issues, including the emergence of resistance and the adverse effects connected with the use of contemporary medications like antibiotics and anti-cancer medications, there is a huge interest in medicinal plants today (15).
Environmental pollution is caused when by-products such as seeds and peels are produced. A significant number of biological components is present in the peel and it contains approximately 26%–30% of the total weight of fruit. This research provided the health benefits of pomegranate peel, and the identification of biological components like phenolic acids, alkaloids, flavonoids, tannins, minerals, dietary fibers, and vitamins were assessed. We found that the peel had cinnamic, butyric, caffeic, erucic, ellagic, ferulic, chlorogenic, and gallic acids. Environmental conditions affected the concentrations and phenolic acid profiles. Pomegranate peel contains different bioactive components like caffeic (20.56 mg), ellagic (35.89 mg), and gallic (123.79 mg) acids. Dietary fiber was used as a natural source and the peel was rich in dietary fibers of approximately 33% to 62%. Dietary fibers included uronic acid, lignin, sugars, and cellulose, but the maximum amount was present in lignin. Neural sugars like galactose, rabinose, and xylose were present in the peel. Uronic acid and cellulose contained the same amount of approximately 16 to 22 mg/100 mg in pomegranate peel. Peel contained gallic acid, punicalagin, ellagitannins, and ellagic acids, showing antibacterial effects against E. coli and S. aureus microbes, which inhibited glycosyltransferases that cause cell death. Peel showed inhibitory effects against Yersinia enterocolitica, S. aureus, L. monocytogenes, and E. coli which was confirmed by in vivo studies (9).
Anti-diabetic activity was done by α-glucosidase assay. Phosphate buffer with 0.07 M molarity and 6.8 pH was prepared with p-NPG substrate and α-glucosidase enzyme (2.0 U m/L and α- glucosidase 2.5 U m/L). Results were measured at 405 nm by ELISA assay. The highest activity was observed in methanol and butanol showed the lowest activity. The greatest activity was exhibited by methanol and butanol extracts. The percentage concentration of extracts provided the highest percentage of methanol extract at 80.5% (29) (25). In the antibacterial assay, S. viridans was used as gram +ve and E. coli as gram –ve bacterial strains. Extracts of methanol and butanol showed resistance against gram +ve bacteria. Peel extract of methanol and butanol showed antibacterial activity against S. viridans. The zone of inhibition was measured in mm of different extracts of P. granatum peel. Maximum zones were shown by butanol and methanol extracts at 0.5 mg/mL is 16 ± 0.39 and 15 ± 0.34, respectively (30).
L. monocytogenes exhibited the lowest bactericidal effects when consumed with 24.7 mg/mL of peel extracts. In our study, photochemistry screening confirmed the presence of phenols and tannins in methanol and n-hexane extract but not in chloroform and butanol fractions. Glycosides, flavonoids, and terpenoids were present in all extracts except n-hexane. Tannins were present in all fractions except chloroform. Tannins were present in butanol and n-hexane but not in methanol and chloroform. Steroids were absent in butanol and chloroform. Previous studies also reported that saponins, steroids, and flavonoids were present in extracts of P. granatum. Our research proved that the antioxidant potential of P. granatum and its fractions was determined by using the DPPH radical scavenging assay (35). Radical scavenging activity was evaluated at different concentrations of fractions. Results were analyzed statistically. Methanol, chloroform, n-hexane, and butanol showed antioxidant potential at 0.5 mg/mL concentrations of 85 ± 0.096, 71 ± 0.029, 65 ± 0.050, and 89 ± 0.019, respectively. When concentration decreased, antioxidant potential also decreased to 80 ± 0.029, 60 ± 0.025, 58 ± 0.049, and 86.6 ± 0.023 at 0.25 mg/mL for methanol, chloroform, n-hexane, and butanol concentration, respectively. Butanol and methanol fractions showed the highest antioxidant activity. The order of antioxidant activity results was butanol > methanol > chloroform > n-hexane. Ascorbic acid was taken as standard which showed radical scavenging percentage at different concentrations, i.e., 0.5, 0.25, 0.125, 0.0625, and 0.03125 mg/mL as 98.9 ± 0.007, 98.5 ± 0.005, 97.3 ± 0.012, 96.6 ± 0.015, and 96 ± 0.014, respectively. The results of anti-inflammatory properties showed that fractions at concentrations of 0.5 mg/mL extracts for methanol, chloroform, n-hexane, and butanol were 90 ± 0.034, 66 ± 0.017, 77 ± 0.060, and 78 ± 0.017, respectively. When concentration decreased, inhibition values also decreased. At 0.25 mg/mL, inhibition decreased to 86 ± 0.016, 60 ± 0.020, 75 ± 0.045, and 72 ± 0.009, respectively, according to fractions. Dicloran was taken as standard which showed its maximum inhibition of 98 ± 0.005, 97.8 ± 0.015, 96.6 ± 0.018, 95 ± 0.019, and 94 ± 0.012 at different concentrations of 0.5, 0.25, 0.125, 0.625, and 0.03125 mg/mL, so dicloran exhibited inhibition percentages of 98%, 97.8%, 96.6%, 95%, and 94% (28).
Docking of ligands obtained from GC-MS was done through AutoDock Vina (36). Compounds that were identified in methanol extract were thymine, 3,5-octadien-2-one, 4H-pyran-4-one, 2,3-dihydro-3,5-dihydroxy-6-methyl, 1H-pyrrole-2,5-dione, diethyl phthalate, benzeneethanamine, N-[(pentafluorophenyl)methylene]-beta.,3,4-tris[(trimethylsilyl)oxy], 2-(2′,4′,4′,6′,6′,8′,8′-heptamethyltetrasiloxan-2′-yloxy)-2,4,4,6,6,8,8,10,10-nonamethylcyclopentasiloxane, 9-octadecenoic acid (Z)-, methyl ester, oxalic acid, 2-ethylhexyl tetradecyl ester, octasiloxane, 1,1,3,3,5,5,7,7,9,9,11,11,13,13,15,15-hexadecamethyl, and more, of which 9-octadecenoic acid (Z)-, methyl ester showed the highest energy and interaction with TXNIP protein. Compounds in n-hexane extract were 2,6-Di-tert-butyl-4-hydroxy-4-methylcyclohexa-2,5-dien-1-one, 7,9-Di-tert-butyl-1-oxaspiro(4,5)deca-6,9-diene-2,8-dione, hexadecanoic acid, methyl ester, n-hexadecanoic acid, octasiloxane, 1,1,3,3,5,5,7,7,9,9,11,11,13,13,15,15-hexadecamethyl, decane, 3,8-dimethyl, bis (2-ethylhexyl) phthalate, arsenous acid, tris(trimethylsilyl) ester, and others. From all of these compounds, bis (2-ethylhexyl) phthalate showed the highest energy and interaction with protein. So, octadecenoic acid (Z)-, methyl ester and bis (2-ethylhexyl) phthalate can be used for making novel drugs against diabetes. The literature reports various studies documenting phytochemical and pharmacological characterizations of P. granatum peel (37–39).
Conclusion and future perspectives
The study substantiates the value of pomegranate fruit peel waste as an economical source of versatile biotherapeutics. Ongoing studies should unlock additional bioactive secondary metabolites for nutraceutical and pharmaceutical applications via green extraction approaches. Further translational research can facilitate the development of new evidence-based drugs, functional foods, and preventive strategies by leveraging pomegranate peel derivatives against inflammation, diabetes, oxidation, and infection.
Statements
Data availability statement
The mass spectrometry data generated and analyzed in this study have been deposited in a publicly accessible repository. Specifically, the raw mass spectrometry files, processed data files, and associated metadata have been uploaded to the MassIVE repository (https://massive.ucsd.edu), which is a public data repository for mass spectrometry datasets.
Author contributions
TAs: Methodology, Investigations, Writing – original draft. AAr: Conceptualization, Methodology, Investigations, Supervision, Writing – original draft. SA: Conceptualization, Formal analyses, Supervision, Writing – original draft. FM: Formal analyses, Writing – original draft. KA: Methodology, Investigations, Writing – original draft. UK: Conceptualization, Formal analyses, Writing – original draft. SR: Methodology, Supervision, Writing – original draft. TAf: Methodology, Investigations, Writing – original draft. AAl: Conceptualization, Methodology, Investigations, Supervision, Writing – original draft. HS: Formal analyses, Investigations, Writing – original draft. MOI: Methodology, Investigations, Writing – original draft. MZ: Conceptualization, Formal analyses, Writing – original draft.
Funding
The author(s) declare financial support was received for the research, authorship, and/or publication of this article. The authors extend their appreciation to the Researchers Supporting project number (RSP2024R502), King Saud University, Riyadh Saudi Arabia for funding this project.
Acknowledgments
The authors acknowledge and extend their appreciation to the Researchers Supporting project number (RSP2024R502), King Saud University, Riyadh Saudi Arabia for funding this project.
Conflict of interest
The authors declare that the research was conducted in the absence of any commercial or financial relationships that could be construed as a potential conflict of interest.
Publisher’s note
All claims expressed in this article are solely those of the authors and do not necessarily represent those of their affiliated organizations, or those of the publisher, the editors and the reviewers. Any product that may be evaluated in this article, or claim that may be made by its manufacturer, is not guaranteed or endorsed by the publisher.
References
1.
Ashfaq K Anees-ur-Rehman M Tariq M Ali N . Evaluation of phenolic contents, cytotoxic, and antioxidant potential of Euphorbia nerrifolia. Int J Nat Med Health Sci. (2022) 1:58–64. doi: 10.52461/ijnms.v1i2.867
2.
Kumari I Kaurav H Chaudhary G . Punica granatum L. (Dadim) Punica granatum L. (Dadim), therapeutic importance of World’s Most ancient fruit plant. J Drug Deliv Ther. (2021) 11:113–21. doi: 10.22270/jddt.v11i3.4832
3.
Ibrahim AM Ghareeb MA . Preliminary phytochemical screening, total phenolic content, in vitro antioxidant and molluscicidal activities of the methanolic extract of five medicinal plants on Biomphalaria alexandrina snails. J Herbs Spices Med Plants. (2020) 26:40–8. doi: 10.1080/10496475.2019.1666769
4.
Bilal M Parveen A Fiaz A Mazhar M . In vitro phytochemical analysis, antimicrobial and antioxidant activity of Mallotus philippinensis. Int J Nat Med Health Sci. (2022) 2:11–6. doi: 10.52461/ijnms.v2i1.1237
5.
Patel A Shadab K Bhise K . Antifungal and antimicrobial activity of pomegranate peel powder. World J Pharm Res. (2017) 6:1424–30. doi: 10.20959/wjpr20174-8233
6.
Gullon B Pintado ME Fernández-López J Pérez-Álvarez JA Viuda-Martos M . In vitro gastrointestinal digestion of pomegranate peel (Punica granatum) flour obtained from co-products: changes in the antioxidant potential and bioactive compounds stability. J Funct Foods. (2015) 19:617–28. doi: 10.1016/j.jff.2015.09.056
7.
Ghauri AO Farrukh U Fatima N Khalid S Kamal S Azhar I . A mini review of phytoconstituents and pharmacological activities of Citrullus lanatus (Thunb.). Int J Nat Med Health Sci. (2023) 2:7–11.
8.
Akhtar S Ismail T Fraternale D Sestili P . Pomegranate peel and peel extracts: chemistry and food features. Food Chem. (2015) 174:417–25. doi: 10.1016/j.foodchem.2014.11.035
9.
Rahmani AH Alsahli MA Almatroodi SA . Active constituents of pomegranates (Punica granatum) as potential candidates in the management of health through modulation of biological activities. Pharm J. (2017) 9:689–95. doi: 10.5530/pj.2017.5.109
10.
Zhou H Zhang Z Qian G Zhou J . Omentin-1 attenuates adipose tissue inflammation via restoration of TXNIP/NLRP3 signaling in high-fat diet-induced obese mice. Fundam Clin Pharmacol. (2020) 34:721–35. doi: 10.1111/fcp.12575
11.
Yu W Chen C Zhuang W Wang W Liu W Zhao H et al . Silencing TXNIP ameliorates high uric acid-induced insulin resistance via the IRS2/AKT and Nrf2/HO-1 pathways in macrophages. Free Radic Biol Med. (2022) 178:42–53. doi: 10.1016/j.freeradbiomed.2021.11.034
12.
Yoshihara E . TXNIP/TBP-2: a master regulator for glucose homeostasis. Antioxidants. (2020) 9:765. doi: 10.3390/antiox9080765
13.
Xiang Y Wang Z Hui Q Gwinn M Vaccarino V Sun YV . DNA methylation of TXNIP independently associated with inflammation and diabetes mellitus in twins. Twin Res Hum Genet. (2021) 24:273–80. doi: 10.1017/thg.2021.42
14.
Munir N Mahmood Z Riaz M Tahir IM Shah SMA Bacha U et al . In vitro evaluation of antimicrobial and cytotoxic potential of Epimedium grandiflorum hydroethanolic extract as natural medicine. Int J Med Sci Public Health. (2022) 2:25–31. doi: 10.52461/ijnms.v2i1.1229
15.
Derakhshan Z Ferrante M Tadi M Ansari F Heydari A Hosseini MS et al . Antioxidant activity and total phenolic content of ethanolic extract of pomegranate peels, juice and seeds. Food Chem Toxicol. (2018) 114:108–11. doi: 10.1016/j.fct.2018.02.023
16.
Kang JH Song KB . Effect of pomegranate (Punica granatum) pomace extract as a washing agent on the inactivation of Listeria monocytogenes inoculated on fresh produce. Int J Food Sci Technol. (2017) 52:2295–302. doi: 10.1111/ijfs.13511
17.
Xylia P Chrysargyris A Botsaris G Tzortzakis N . Mint and pomegranate extracts/oils as antibacterial agents against Escherichia coli O157: H7 and Listeria monocytogenes on shredded carrots. J Food Saf. (2018) 38:e12423. doi: 10.1111/jfs.12423
18.
Ariza MT Reboredo-Rodríguez P Cervantes L Soria C Martínez-Ferri E González-Barreiro C et al . Bioaccessibility and potential bioavailability of phenolic compounds from achenes as a new target for strawberry breeding programs. Food Chem. (2018) 248:155–65. doi: 10.1016/j.foodchem.2017.11.105
19.
Emam-Djomeh Z Moghaddam A Yasini Ardakani SA . Antimicrobial activity of pomegranate (Punica granatum L.) peel extract, physical, mechanical, barrier and antimicrobial properties of pomegranate peel extract-incorporated sodium caseinate film and application in packaging for ground beef. Packag Technol Sci. (2015) 28:869–81. doi: 10.1002/pts.2145
20.
Orgil O Spector L Holland D Mahajna J Amir R . The anti-proliferative and anti-androgenic activity of different pomegranate accessions. J Funct Foods. (2016) 26:517–28. doi: 10.1016/j.jff.2016.08.024
21.
Rahimi AM Jafarpour M Pessarakli M . Morpho-pomological and chemical properties of pomegranate (Punica granatum L.) cultivars in Iran. J Plant Nutr. (2017) 40:1437–42. doi: 10.1080/01904167.2016.1269181
22.
Ahmad S Shabbir A Tareen N Ahmad S Chohan MA . Plant-derived bioactive compounds as skin photo protection agents. Int J Nat Med Health Sci. (2022) 1:46–55. doi: 10.52461/ijnms.v1i2.866
23.
Iqbal MO Manzoor M Mumtaz A Riaz R Arshad S Khan IA et al . Evaluation of the hepatoprotective activity of hydroalcoholic extract of Alhagi camelorum against valproic acid-induced hepatotoxicity in rats. Biomed Pharmacother. (2022) 150:112953. doi: 10.1016/j.biopha.2022.112953
24.
Carvalho JC Fernandes CP Daleprane JB Alves MS Stien D Dhammika Nanayakkara N . Role of natural antioxidants from functional foods in neurodegenerative and metabolic disorders. Oxid Med Cell Longev. (2018) 2018:1459753. doi: 10.1155/2018/1459753
25.
Rehman MAU Khan I . Medicinal and pharmacological potential of guava leaf powder, a review. Int J Med Sci Public Health. (2022) 1. doi: 10.52461/ijnms.v1i2.834
26.
Kumar M Dandapat S Ranjan R Kumar A Sinha M . Plant mediated synthesis of silver nanoparticles using Punica granatum aqueous leaf extract. J Microbiol Exp. (2018) 6:175–8. doi: 10.15406/jmen.2018.06.00211
27.
Jayaprakash A Sangeetha R . Phytochemical screening of Punica granatum Linn. Peel extracts. J Acad Ind Res. (2015) 4:160–2.
28.
Ali Redha A Hasan A Mandeel Q . Phytochemical determinations of pomegranate (Punica granatum) rind and aril extracts and their antioxidant, antidiabetic and antibacterial activity. Nat Prod Chem Res. (2018) 6:1–9. doi: 10.4172/2329-6836.1000332
29.
Alsataf S Başyiğit B Karaaslan M . Multivariate analyses of the antioxidant, antidiabetic, antimicrobial activity of pomegranate tissues with respect to pomegranate juice. Waste Biomass Valor. (2021) 12:5909–21. doi: 10.1007/s12649-021-01427-9
30.
Kupnik K Leitgeb M Primožič M Postružnik V Kotnik P Kučuk N et al . Supercritical fluid and conventional extractions of high value-added compounds from pomegranate peels waste: production, quantification and antimicrobial activity of bioactive constituents. Plan Theory. (2022) 11:928. doi: 10.3390/plants11070928
31.
Zardecki C Dutta S Goodsell DS Lowe R Voigt M Burley SK . PDB-101: educational resources supporting molecular explorations through biology and medicine. Protein Sci. (2022) 31:129–40. doi: 10.1002/pro.4200
32.
Kim S Chen J Cheng T Gindulyte A He J He S et al . PubChem in 2021: new data content and improved web interfaces. Nucleic Acids Res. (2021) 49:D1388–95. doi: 10.1093/nar/gkaa971
33.
Jejurikar BL Rohane SH . Drug designing in discovery studio. Asian J Res Chem. (2021) 14:135–8. doi: 10.5958/0974-4150.2021.00025.0
34.
Di Muzio E Toti D Polticelli F . DockingApp: a user friendly interface for facilitated docking simulations with AutoDock Vina. J Comput Aided Mol Des. (2017) 31:213–8. doi: 10.1007/s10822-016-0006-1
35.
Jabeen Q Haider SI Asif A Rasheed R Gul S Arshad S . Geranium wallichianum D. don ex sweet ameliorates rheumatoid arthritis by curtailing the expression of COX-II and inflammatory cytokines as well as by alleviating the oxidative stress. Dose Response. (2022) 20:15593258221112649. doi: 10.1177/15593258221112649
36.
Amaro RE Baudry J Chodera J Demir Ö McCammon JA Miao Y et al . Ensemble docking in drug discovery. Biophys J. (2018) 114:2271–8. doi: 10.1016/j.bpj.2018.02.038
37.
Maphetu N Unuofin JO Masuku NP Olisah C Lebelo SL . Medicinal uses, pharmacological activities, phytochemistry, and the molecular mechanisms of Punica granatum L. (pomegranate) plant extracts: a review. Biomed Pharmacother. (2022) 153:113256. doi: 10.1016/j.biopha.2022.113256
38.
Montefusco A Durante M Migoni D De Caroli M Ilahy R Pék Z et al . Analysis of the phytochemical composition of pomegranate fruit juices, peels and kernels: a comparative study on four cultivars grown in southern Italy. Plan Theory. (2021) 10:2521. doi: 10.3390/plants10112521
39.
Singh J Kaur HP Verma A Chahal AS Jajoria K Rasane P et al . Pomegranate peel phytochemistry, pharmacological properties, methods of extraction, and its application: a comprehensive review. ACS Omega. (2023) 8:35452–69. doi: 10.1021/acsomega.3c02586
Summary
Keywords
Punica granatum , TXNIP, diabetes, Staphylococcus viridans , phytochemicals, biological activities
Citation
Aslam T, Arif A, Arshad S, Muccee F, Ahmad K, Iqbal MO, Khalil U, Razak S, Afsar T, Almajwal A, Shafique H and Zain M (2024) Discovering the anti-diabetic potential of pomegranate peel metabolites by examining molecular interplay with the thioredoxin-interacting protein. Front. Med. 10:1322450. doi: 10.3389/fmed.2023.1322450
Received
16 October 2023
Accepted
18 December 2023
Published
10 September 2024
Volume
10 - 2023
Edited by
Allah Nawaz, Joslin Diabetes Center and Harvard Medical School, United States
Reviewed by
Kamala Badalova, Azerbaijan Medical University, Azerbaijan
Muhammad Shahzeb Khan, Gdansk University of Technology, Poland
Updates
Copyright
© 2024 Aslam, Arif, Arshad, Muccee, Ahmad, Iqbal, Khalil, Razak, Afsar, Almajwal, Shafique and Zain.
This is an open-access article distributed under the terms of the Creative Commons Attribution License (CC BY). The use, distribution or reproduction in other forums is permitted, provided the original author(s) and the copyright owner(s) are credited and that the original publication in this journal is cited, in accordance with accepted academic practice. No use, distribution or reproduction is permitted which does not comply with these terms.
*Correspondence: Shafia Arshad, shafia.arshad@iub.edu.pk
Disclaimer
All claims expressed in this article are solely those of the authors and do not necessarily represent those of their affiliated organizations, or those of the publisher, the editors and the reviewers. Any product that may be evaluated in this article or claim that may be made by its manufacturer is not guaranteed or endorsed by the publisher.